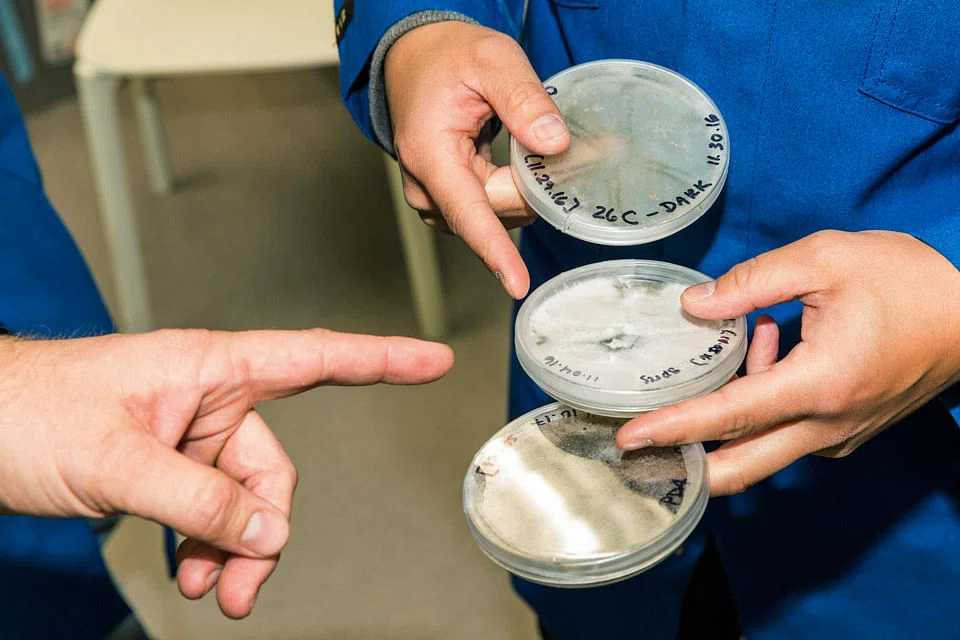

California startup offers longer-shelf-life solution
Santa Barbara, California
WHAT if a Florida tomato could be left on the vine long enough to turn red and fully develop its flavour - and still be ripe and juicy when it arrived at a grocery store in New York days later?
That is precisely the promise of a startup in southern California. Apeel Sciences aims to make obsolete the gas, wax and other tricks growers use to keep fruits and vegetables fresh over time.
Share with us your feedback on BT's products and services
TRENDING NOW

DBS Q1 net profit up 1% at S$2.93 billion on record wealth management fees, beating forecasts

Family office for US$12 billion Tetra Pak Fortune exits Hong Kong

Thai and Vietnamese farmers may stop planting rice because of the Iran war. Here’s why

Deloitte’s Lee Boon Teck succeeds Teo Ser Luck as president of Singapore’s national accounting body